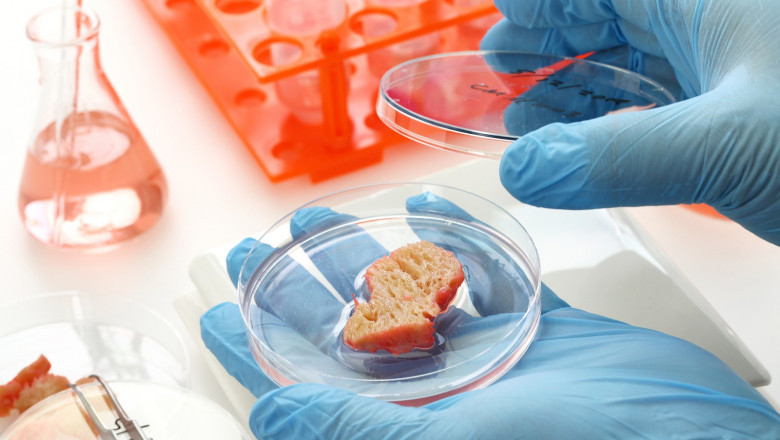

views
Single Cell Protein Market: Introduction
A recent study published by Transparency Market Research on the single cell protein market includes ASEAN industry analysis and opportunity assessment for 2020-2030. Revenue generated from the single cell protein market in ASEAN was valued over ~US$ 95.7 Bn in 2020, which is estimated to rise at a CAGR of ~9.3%, to reach US$ 232 Bn by 2030.

Revenue generated from the single cell protein market in Europe was valued at ~US$ 2,390 Mn in 2020, which is estimated to rise at a CAGR of ~7.3% to reach US$ 4,845.2 Mn by 2030.
Request A Sample- https://www.transparencymarketresearch.com/sample/sample.php?flag=S&rep_id=32618
Healthy Lifestyles and Rising Consumer Awareness toward Preventative Health
Rising awareness about high-quality food that contributes to good health and constitutes nutritional value lead to consumers inclining toward healthy eating regimes. Obesity is increasingly becoming a concern of the population today, owing to sedentary lifestyles and food eating habits. Consumers today demand food that is nutritious with increased protein content as protein helps in weight management.
Single cell protein provides the necessary content of protein, along with added nutrients to meet consumer demands. Increasing popularity of protein rich products among millennials, along with the rising number of significant gym subscriptions boosts the demand for single cell protein.
- According to the World Health Organization, obesity and overweight are the main cause of cardiovascular diseases known to be the number one cause of death globally
Shifting Customer Demands for Transparency and Safety Assurance
The current health trends lead to an increased concern regarding food safety with increased awareness about regulations. Consumers today make informed decisions about products that they are buying and looking for products that are safe and meet high regulation standards.
With the help of technology, consumers are tracing the journey of food from source to consumption for ensuring safety. With single cell protein being an unconventional source of protein claiming to have additional nutrients, customers demand transparency and safety assurance for food as well as feed products.
- Parry Nutraceuticals provides complete transparency of its offerings from the sourcing of ingredients till the delivery of products
Products with Increased Applications Gaining Traction
Single cell protein is flexible in composition, and can be customized according to the required protein profile. Characteristics of the product are expected to encourage major functional food and beverage manufacturers to use single cell protein in their offerings, as it is more cost-effective and fortifying than other animal and plant protein sources.
The production of single cell protein is not geography-specific, which results into streamlined volume supply and easy scaling-up of the output volume at any given time, making it useful for the fortified food and beverages industry. It has increased applications in this industry, along with applications in human and animal nutrition.
Purchase A Report- https://www.transparencymarketresearch.com/checkout.php?rep_id=32618<ype=S
Challenges for Single Cell Protein Manufacturers
Availability of alternatives to hinder sales of single cell protein: Alternative sources for protein in the human food and feed market are increasing with the rising demand for consumers for protein in their diets as well as for feedstock. Different companies are involved in manufacturing and marketing protein powders, protein shakes, and supplements that are made from peas, rice, soybeans, potatoes, and hemp. These alternatives are easily available and are becoming popular, with whey drinks being in demand for increasing protein content of end products. These alternatives are available in different flavors with added minerals and vitamins, attracting millennials that demand food products filled with nutrients without compromising on taste or mouthfeel. Easy availability and robust promotion of these alternatives may prove to hinder sales of single cell protein.